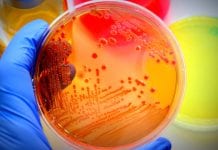

chronic pain Related News
Overprescribing opioids is a thing – it’s time to stop it
A research team from Keele University, UK, has been awarded with a £2.4 million (~€2.7) grant to help reduce the overprescribing of opioids.
The National...
Phantom limb pain treatment: rerouting nerves during amputation
Ohio State University find life-altering benefits by rerouting nerves during amputation - could this be a form of phantom limb pain treatment?
Doctors at The...
Pseudoachondroplasia dwarfism and new treatment targets
Disrupting the self-perpetuating cellular loop of endoplasmic reticulum stress & inflammation of pseudoachondroplasia dwarfism may be the key to therapeutic advances.
Pseudoachondroplasia dwarfism is a...
World Arthritis Day: Arthritis facts and ways to combat the condition
With today being World Arthritis day, Health Europa highlights ways in which those suffering can combat the condition.
In the UK, roughly 10 million people...
Could osteoporosis be linked to development of dementia?
In almost 60,000 patients, the risk of dementia could be linked to osteoporosis, according to an investigation by the Epidemiology Team of IQVIA, Frankfurt,...
Survey reveals medical cannabis reduced painkiller use in older adults
A new study has revealed using medical cannabis (or marijuana) substantially reduced chronic pain and dependence on opioid painkillers in 65% of older adults.
Researchers...